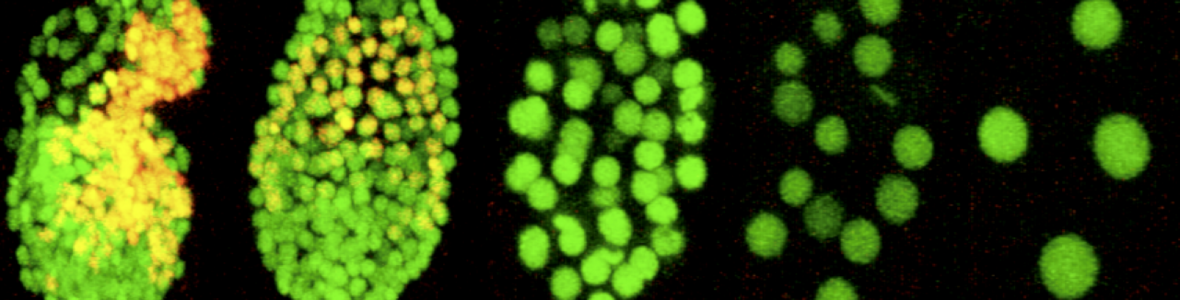
banner image

Genetics and Epigenetics Academics
G&E students typically complete their degree in 5 - 6 years. Students complete coursework and a thesis proposal-based Preliminary Exam within Years 1 and 2. Years 3+ are spent primarily on thesis research, supplemented by a variety of seminars and other activities that promote scientific interactions and continued development of communication and other career-relevant skills. After successfully passing the prelim exam, trainees become eligible for GEN-TG support.
Requirements | Typical Timetable | Suggested Electives
Requirements for students in the G&E program
- General CAMB Requirements
- BIOM 5550: Regulation of the Genome
- BIOM 6000: Cell Biology & Biochemistry
- BIOM 6100 (or the equivalent): Foundations in Statistics
- CAMB 6050 (PhD only): Cell and Molecular Biology First Year Seminar
- BIOM 5100 (MD/PhD Combined Degree only): Case Studies in Translational Research
- CAMB 5420 (Combined Degree only): Topics in Molecular Medicine
- CAMB 5500: Genetic Principles
- GCB 5350: Introduction to Bioinformatics or CAMB 7140: DIYtranscriptomics
- Electives chosen from any relevant CAMB or BGS Courses and Curricula offerings, depending on interest and background.
This information can also be found on the G&E Catalog page.
Requirements | Typical Timetable | Suggested Electives
Typical G&E Course Timetable
| Fall | Spring | Summer | |
|---|---|---|---|
| Year 1 | BIOM 6000 CAMB 6050 Lab Rotation |
BIOM 5550 CAMB 5500 Two Lab Rotations |
Lab Rotation or Pre-Dissertation Research |
| Year 2 |
GCB 5350 |
CAMB 7140(if didn't take GCB 535) CAMB 6950 Electives Pre-Dissertation Research Candidacy Examination |
Dissertation research |
| Year 3+ | Dissertation research | Dissertation research | Dissertation research |
Requirements | Typical Timetable | Suggested Electives
Suggested Elective Courses
Whereas any CAMB courses can be used to fulfill elective requirements (depending on the student's interests and background), the following courses are likely to be of particular relevance. Students will receive guidance from G&E leadership and faculty when choosing electives.
- CAMB 4830: Epigenetics
- CAMB 4850: The RNA World
- CAMB 5120: Cancer Biology and Genetics
- CAMB 5340: Modeling Human Disease in Animals
- CAMB 6080: Seminar in Regulation of Eukaryotic Gene Expression
- CAMB 6950: Scientific Writing
- CAMB 7130: Neuroepigenetics
- CAMB 7520: Genomics seminar
- CIT 5900: Programming Languages and Techniques
- EPID 5750: Introduction to Genetic Epidemiology
- GCB 5340: Experimental Genome Science
- GCB 5360: Computational Biology
- GCB 5770: Advanced Epigenetics Technology